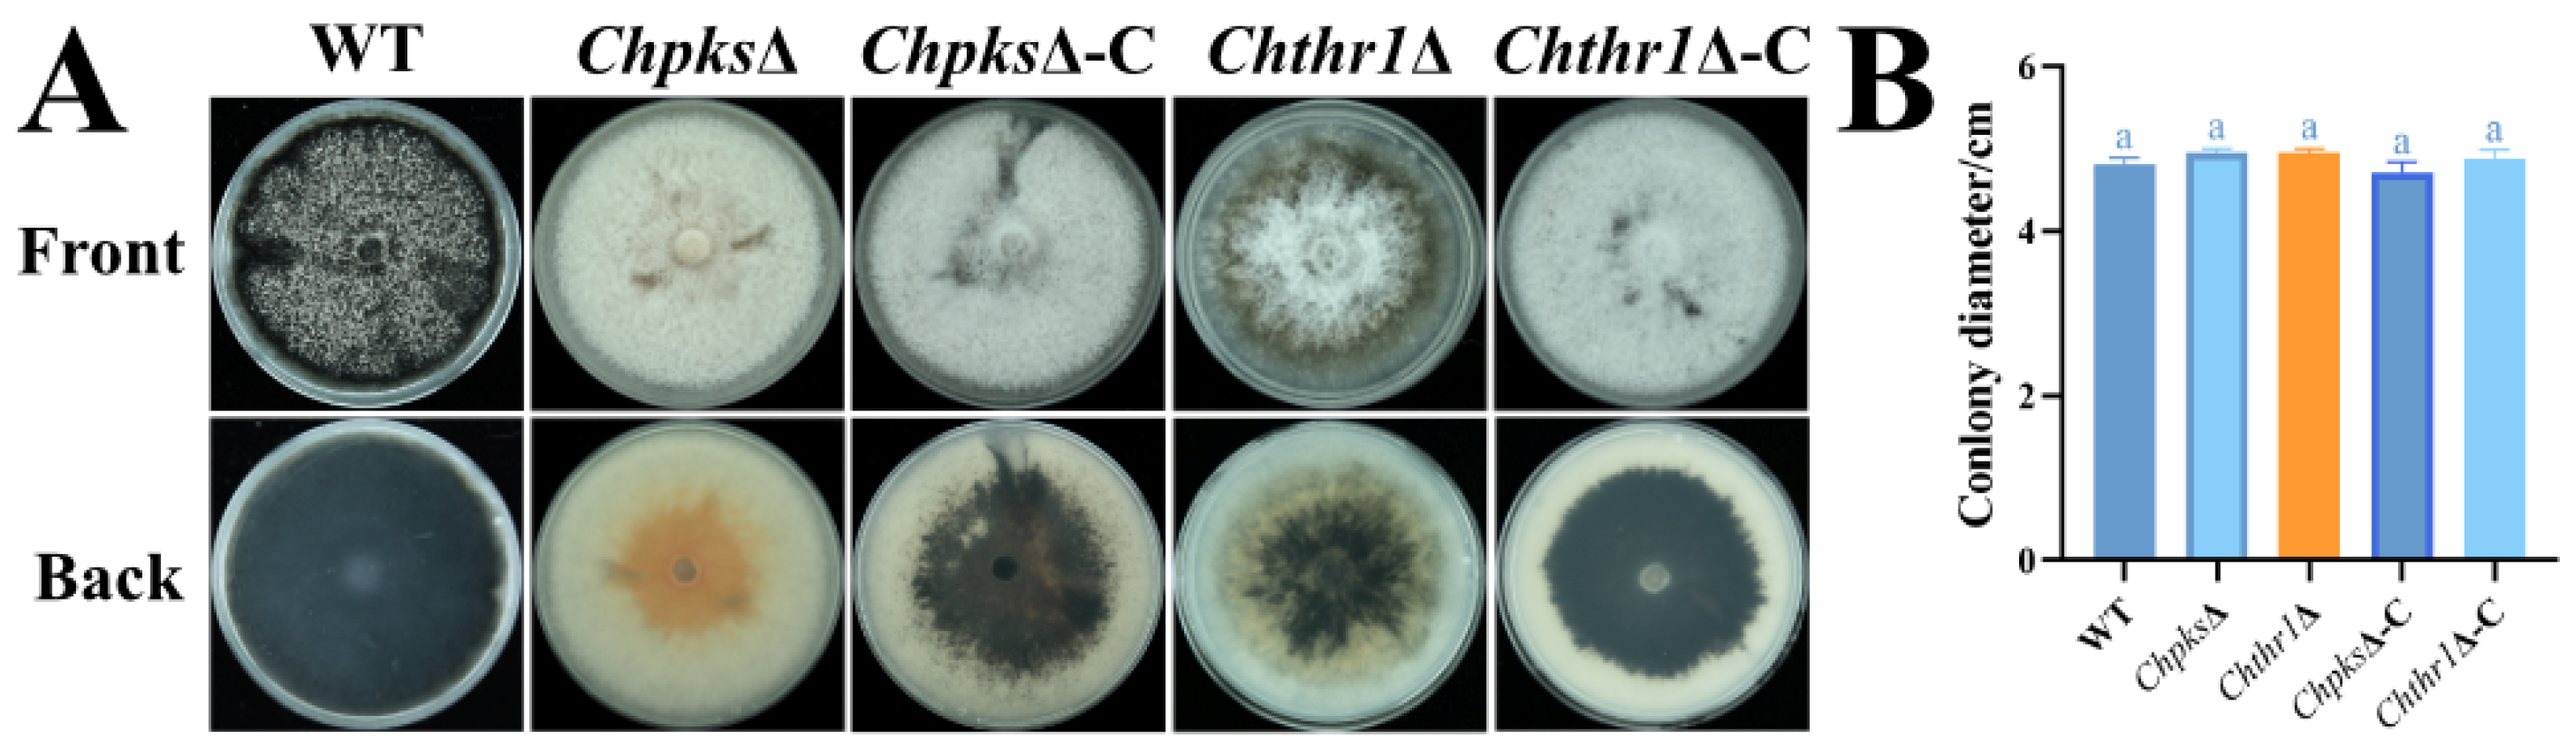
Ijms 24 15890 g003

Abstract
Colletotrichum higginsianum is a major pathogen causing anthracnose in Chinese flowering cabbage (Brassica parachinensis), posing a significant threat to the Chinese flowering cabbage industry. The conidia of C. higginsianum germinate and form melanized infection structures called appressoria, which enable penetration of the host plant’s epidermal cells. However, the molecular mechanism underlying melanin biosynthesis in C. higginsianum remains poorly understood. In this study, we identified two enzymes related to DHN-melanin biosynthesis in C. higginsianum: ChPks and ChThr1. Our results demonstrate that the expression levels of genes ChPKS and ChTHR1 were significantly up-regulated during hyphal and appressorial melanization processes. Furthermore, knockout of the gene ChPKS resulted in a blocked DHN-melanin biosynthetic pathway in hyphae and appressoria, leading to increased sensitivity of the ChpksΔ mutant to cell-wall-interfering agents as well as decreased turgor pressure and pathogenicity. It should be noted that although the Chthr1Δ mutant still exhibited melanin accumulation in colonies and appressoria, its sensitivity to cell-wall-interfering agents and turgor pressure decreased compared to wild-type strains; however, complete loss of pathogenicity was not observed. In conclusion, our results indicate that DHN-melanin plays an essential role in both pathogenicity and cell wall integrity in C. higginsianum. Specifically, ChPks is crucial for DHN-melanin biosynthesis while deficiency of ChThr1 does not completely blocked melanin production.
1. Introduction
Colletotrichum, a member of the Ascomycete phylum, is a kind of widespread phytopathogen that can infect various crops worldwide [1]. In 2012, it was recognized as one of the top 10 fungal pathogens due to its scientific and economic significance [1]. Anthracnose caused by Colletotrichum higginsianum poses a significant threat to Chinese flowering cabbage (Brassica parachinensis) cultivation in South China, leading to reduced crop quality and yield [2]. The annual yield losses due to anthracnose outbreaks can reach up to 40%, severely impacting the development of the Chinese flowering cabbage industry in this region [2]. C. higginsianum has a hemibiotrophic lifestyle and has been found to infect various cruciferous plants including model plant Arabidopsis [3,4,5]. Moreover, genomic and transcriptomic data for C. higginsianum have been published and are readily accessible for genetic manipulation studies [6,7], making significant contributions to our understanding of the mechanisms underlying interactions between plant pathogenic fungi and host plants.
Melanin is a macromolecular pigment produced by various fungi through three pathways: polyketide (DHN), 3,4-dihydroxyphenyl-alanine (L-DOPA) and tyrosine degradation synthetic pathways [8,9,10]. Previous studies have demonstrated that C. higginsianum produces DHN-melanin through the polyketide synthase pathway [5]. The biosynthetic pathway involves the polymerization of acetyl-CoA and malonyl-CoA by polyketide synthase (Pks) to form 1,3,6,8-Tetrahydroxynaphthalene (T4HN). T4HN then undergoes enzymatic conversions catalyzed by tetrahydroxynaphthalene reductase (Thnr), scytalone dehydratase (Scd), and trihydroxynaphthalene reductase (Thr1) to produce vermelone. Finally, vermelone is dehydrated and polymerized to form DHN-melanin [10,11]. It has been observed in related fungal species that deficiencies or loss of enzymes involved in this pathway can result in blocked biosynthesis of DHN-melanin [8,12,13]. However, the specific role played by these enzymes in DHN-melanin biosynthesis in C. higginsianum remains poorly understood and requires further research.
Melanin is an integral component of the cell wall rather than an independent entity [14], capable of covalently cross-linking with polysaccharide components within it [15,16]. In fungi, there exists a direct interaction between melanin and chitin—a crucial constituent of the fungal cell wall [17]. Reports suggest that chitin acts as a scaffold for melanin deposition within the fungal cell wall contributing to its fixation [18,19]. Additionally, melanin deposited on the fungal cell wall effectively enhances its integrity against various environmental stresses such as heavy metals, ultraviolet (UV) irradiation, and enzymatic lysis [8,9,20]. For example, mutants lacking melanin in Botrytis cinerea exhibit increased sensitivity to agents that interfere with cell wall integrity [21]. In terms of pathogenicity, proper appressorium formation and maintenance of high turgor pressure are crucial for successful infection by fungi like C. higginsianum and Magnaporthe oryzae [22,23,24]. Melanization primarily depends on melanin deposition in the cell wall [25]. Impaired melanin synthesis in M. oryzae inhibits proper appressorium melanization, resulting in reduced intracellular turgor pressure and decreased pathogenicity due to failure in penetrating host plant epidermal cells [24]. Similarly, deficiency of the gene THR1 in C. lagenarium impairs DHN-melanin production and nonmelanized appressoria formation leading to a notable reduction in pathogenicity [26]. Conversely, in C. gloeosporioides, deletion of CgCmr1 and CgPks1 lead to unmelanization and decreased turgor pressure in the appressoria, while had no effect in pathogenicity [27]. Given the unclear relationship between melanin, cell wall integrity, and pathogenicity in C. higginsianum, further research is crucial for elucidating the role of melanin in this particular species.
In this study, we aimed to investigate the role of two enzymes (ChPks and ChThr1) involved in DHN-melanin biosynthesis in C. higginsianum. The expression patterns of genes ChPKS and ChTHR1 were analyzed using the qPCR technique. Gene knockout and complementation strains were constructed for both genes to assess their impact on DHN-melanin biosynthesis as well as growth, development, and pathogenicity in C. higginsianum. The main goal of this research is to gain a better understanding of the molecular mechanisms underlying DHN-melanin biosynthesis and its relationship with cell wall integrity and pathogenicity in C. higginsianum. This knowledge will contribute to improve our understanding of the pathogenesis in anthracnose disease of cruciferous plants. Ultimately, it can aid in developing more effective control strategies against this disease.
2. Results
2.1. Identification and Characterization of ChPks and ChThr1 in C. higginsianum
Using the BLASTp search on NCBI, we identified a homologue of the C. graminicola PKS1 protein (XP_008093079) in C. higginsianum, which we named ChPks (XP_018155915). ChPks consists of a coding sequence of 2198 amino acids in length and contains six characteristic domains, including ACP transacylase domain (SAT), acyl transferase domain (PksD), iterative type I PKS product template domain (PT_fungal_PKS), thioesterase domain (EntF) and two phosphopantetheine attachment site (PP) (Figure 1A). The results of phylogenetic tree analysis demonstrated that ChPks and Pks homologues from C. graminicola, C. orbiculare (TDZ26149) and Verticillium dahliae (XP_009649862) shared high similarity (Figure 1C).
Figure 1.
Bioinformatics analyses of ChPks and ChThr1 in Colletotrichum higginsianum. (A) Pfam domain analysis of ChPks, including SAT, PksD, PT_fungal_PKS, two PP domains, and EntF domain. (B) Phylogenetic tree analysis of ChPks and its homologues in C. graminicola, C. orbiculare, V. dahliae, Gaeumannomyces tritici, Pyricularia oryzae, Drepanopeziza brunnea, B. cinerea and Sclerotinia sclerotiorum. (C) Pfam domain analysis of ChThr1 with a Rossmann-fold NAD(P)-binding domain. (D) Phylogenetic tree analysis of ChThr1 and its homologues in C. fioriniae, V. alfalfae, V. dahliae, P. oryzae, S. sclerotiorum, B. cinerea and Talaromyces marneffei, along with the Thnr homologues in B. cinerea and V. dahliae.
Similarly, we performed a BLASTp search on NCBI using the Sclerotinia sclerotiorum Thr1 (XP_001586798) protein sequence and identified a homologue in C. higginsianum, referred to here as ChThr1 (XP_018155910). ChThr1 was 278 amino acids in length and had a rossmann-fold NAD(P)-binding domain (Figure 1B). Because trihydroxynaphthalene reductase (Thr1) and tetrahydroxynaphthalene reductase (Thnr) had high sequence similarity, we selected Thr1 and Thnr from a number of fungi for phylogenetic analysis. The results showed that ChThr1 aggregated with the Thr1 from other fungal species, and ChThr1 had high degree of similarity with Thr1 homologues from C. fioriniae (XP_007595358), V. alfalfae (XP_003008893) and V. dahliae (XP_009649855) (Figure 1D).
2.2. Expression of Genes ChPKS and ChTHR1 Is Up-Regulated during Melanization
The hyphae of C. higginsianum gradually melanization after 7~10 d of incubation in PDB liquid medium. To assess the expression patterns of genes ChPKS and ChTHR1 during hyphae melanization, we used real-time quantitative PCR (RT-qPCR) to determine the expression levels of genes ChPKS and ChTHR1 in hyphae cultured for 7~10 d. The results showed a significant up-regulation in the expression levels of both genes, ChPKS and ChTHR1, during hyphal melanization (Figure 2A,C). Specifically, compared to 7 d, the expression level of gene ChPKS at 10 d was up-regulated by approximately 11 fold (Figure 2A), while gene ChTHR1 was up-regulated by approximately 5 fold (Figure 2C).
Figure 2.
Expression analyses of genes ChPKS and ChTHR1 during hypha and appressorium melanization. (A,B) Expression patterns of genes ChPKS and ChTHR1 during hypha melanization with ACTIN as the endogenous reference gene. (C,D) Expression patterns of genes ChPKS and ChTHR1 during appressorium melanization with ACTIN as the endogenous reference gene. Error bars represent standard deviations from three replicates, experimental data were analyzed by one-way ANOVA. Different letters indicate a significant difference at p < 0.05.
Subsequently, the expression patterns of genes ChPKS and ChTHR1 were investigated during infection. The results reveled a significant up-regulation in the expression levels of both genes after 8 h post-incubation (hpi) (Figure 2B,D), which coincided with the initiation of appressorium melanization. Furthermore, gene ChTHR1 exhibited a significant up-regulation at 40 hpi (Figure 2D). Meanwhile, the ChThr1-mCherry signal was detected in appressoria during appressorium melanization and biotrophic infection phase (Figure S2). These findings suggest its potential involvement in the biotrophic infection phase beyond appressorium melanization of C. higginsianum.
Additionally, we determine the expression of genes ChPKS and ChTHR1 using β-TUBULIN as the endogenous reference gene, which eventually resulted in an expression pattern similar to that with ACTIN as the endogenous reference gene (Figure S1).
2.3. ChPks and ChThr1 Are Involved in DHN-Melanin Biosynthesis
To evaluate the role of ChPks and ChThr1 in DHN-melanin biosynthesis in C. higginsianum, we employed ATMT (Agrobacterium tumefaciens mediated transformation) to knockout the genes ChPKS and ChTHR1 in the WT strain (Figure S3A,B). PCR was used to confirm that the gene ChPKS and ChTHR1 were knockout in their respective mutants (Figure S4A–F). Using the PKS-probe and the THR1-probe, a single hygromycin phosphotransferase gene was detected by Southern blotting to replace the genes ChPKS and ChTHR1 in the ChpksΔ and Chthr1Δ mutant genomes, respectively (Figure S4G,H). As depicted in Figure 3A, the colony of the ChpksΔ mutant exhibited a complete absence of melanization and displayed an orange-yellow coloration compared to the WT strain. Conversely, while the colony of the Chthr1Δ mutant displayed reduced melanization ability, it did not completely lose its capacity for DHN-melanin biosynthesis. The deficiencies observed in both mutants were restored in the complementation strains (Figure 3A). Additionally, TEM (transmission electron microscopy) analysis revealed that DHN-melanin deposits formed a dense layer on the cell wall of WT strains (Figure 4). In contrast, no melanin layer was detected on the cell wall of the ChpksΔ mutant (Figure 4), although there were still some reduced numbers of melanin deposits present on the cell wall of the Chthr1Δ mutant when compared to WT strains (Figure 4). Since both ChThr1 and ChThnr contain the conserved core motifs of the short-chain dehydrogenase/reductase (SDR) family, we speculate that ChThnr will partially supplement the role of ChThr1 in the Chthr1Δ mutant. However, the expression level of gene ChTHNR was notably down-regulated in the Chthr1Δ mutant (Figure S5).
Figure 3.
Defects in hyphae melanization of the ChpksΔ and Chthr1Δ mutants. (A) Colony morphology of the WT, ChpksΔ, Chthr1Δ, ChpksΔ-C and Chthr1Δ-C strains grown on PDA. (B) Colony diameters for the indicated strains on PDA. Error bars represent standard deviations from three replicates. The experimental data were analyzed using one-way ANOVA. Different letters indicate a significant difference at p < 0.05.
Figure 4.
TEM (transmission electron microscopy) analysis of WT, ChpksΔ and Chthr1Δ strains. The images below each show the region enclosed by the enlarged orange box. Arrows indicate cell wall melanin deposition, and bars represent a scale of 2 μm.
Furthermore, we investigated the impact on vegetative growth caused by deficiencies in ChPks and ChThr1. After cultivation on PDA medium for 5 d, there was no significant difference in colony diameter between both the ChpksΔ and Chthr1Δ mutants compared to the WT strain (Figure 3B). These findings suggest that deficiency or disruption of either gene inhibits DHN-melanin synthesis; however, DHN-melanin synthesis is completely blocked only in the ChpksΔ mutant.
2.4. Melanin Is Essential for Cell Wall Integrity in C. higginsianum
Previous studies have shown that melanin accumulation enhances cell wall integrity, thereby helping the fungus to defend a wide range of abiotic stresses [8,9,10]. Therefore, we analyzed the growth of the WT, ChpksΔ, Chthr1Δ, ChpksΔ-C and Chthr1Δ-C strains under the stresses of CFW (calcofluor white), sodium dodecyl sulfate (SDS) and CR (congo red). After culturing for 5 d, we observed significantly increased growth inhibition rates compared to WT, ChpksΔ-C and Chthr1Δ-C strains (Figure 5A,B). These results indicate that the ChpksΔ and Chthr1Δ mutants displayed higher sensitivity to these cell-wall-interfering agents (CFW, SDS, CR). This suggests that the disruption of DHN-melanin biosynthesis caused by the knockout of genes ChPKS and ChTHR1 affected the cell wall integrity of C. higginsianum.
Figure 5.
Sensitivity analysis of the ChpksΔ and Chthr1Δ mutants to cell wall stresses. (A) Colony morphology of the WT, ChpksΔ, Chthr1Δ, ChpksΔ-C and Chthr1Δ-C strains grown on PDA with 200 μg·mL−1 calcofluor white (CFW), 0.01% SDS, and 200 μg·mL−1 Congo red (CR). (B) Statistical analysis of inhibition rates of these strains under different stress conditions. Error bars represent standard deviations from three replicates. The experimental data were analyzed by one-way ANOVA. Different letters indicate significant difference at p < 0.05.
2.5. Analysis of Conidiation, Appressorium Formation and Morphology, Turgor Pressure in ChpksΔ and Chthr1Δ Mutants
To further investigate the function of ChPks and ChThr1 in C. higginsianum, we conducted an analysis on the conidiation and appressorium formation rate of the ChpksΔ and Chthr1Δ mutant. The results revealed a significant decrease in conidiation for both the ChpksΔ and Chthr1Δ mutants compared to the WT strain. Specifically, when cultured on mathur medium for 5 d, the WT strain produced 8.92 × 106·mL−1 conidia, while the conidiation of the ChpksΔ and Chthr1Δ mutants was only 4.83 × 106·mL−1 and 4.38 × 106·mL−1, respectively (Figure 6A). However, it is worth noting that neither absence of either ChPks nor absence of ChThr1 had any effect on appressorium formation rate (Figure 6B). We observed that only the appressoria of the ChpksΔ mutant lost their melanization ability compared to those formed by WT and Chthr1Δ strains (Figure 6C).
Figure 6.
Conidiation, appressorium formation, morphology, and turgor pressure of the ChpksΔ and Chthr1Δ mutants. (A) Conidiation of the WT, ChpksΔ, Chthr1Δ, ChpksΔ-C and Chthr1Δ-C strains grown on mathur medium for 5 d. (B) Appressorium formation rates of the WT, ChpksΔ, Chthr1Δ, ChpksΔ-C and Chthr1Δ-C strains. (C) Appressorium morphology of the WT, ChpksΔ, Chthr1Δ, ChpksΔ-C and Chthr1Δ-C strains. (D) Appressorium collapse rates of the WT, ChpksΔ, Chthr1Δ, ChpksΔ-C and Chthr1Δ-C strains under glycerol concentration from 1 M to 4 M. Error bars represent standard deviations from three replicates. The experimental data were analyzed by one-way ANOVA. Different letters indicate significant difference at p < 0.05.
Due to the crucial role of DHN-melanin in appressorium turgor pressure accumulation, we conducted a glycerol cytorrhysis assay to assess the appressorium turgor pressure in the ChpksΔ and Chthr1Δ mutants. The results revealed that under 1 M glycerol concentration, the collapse rates of ChpksΔ and Chthr1Δ mutant appressoria were 33.1% and 13.6%, respectively, whereas WT, ChpksΔ-C and Chthr1Δ-C strains exhibited only approximately 3% collapse (Figure 6D). Similarly, at higher concentrations of glycerol (2 M and 3 M), both ChpksΔ and Chthr1Δ mutants displayed significantly higher rates of appressorium collapse compared to WT, ChpksΔ-C and Chthr1Δ-C strains. Additionally, it was observed that under conditions with a glycerol concentration of 1 M or 2 M, the appressoria collapse rate of Chthr1Δ mutant was notably higher compare to the WT strain (Figure 6D). In conclusion, our findings demonstrate that both ChPks and ChThr1 play essential roles in conidiation within C. higginsianum. The absence of DHN-melanin biosynthesis in the ChpksΔ mutant impedes appressorium melanization as well as turgor pressure accumulation. On the other hand, the Chthr1Δ mutant capable of forming melanized appressoria; however, it exhibits reduced turgor pressure potentially due to limited inhibition of DHN-melanin biosynthesis.
2.6. ChPks and ChThr1 Are Enssential for Pathogenicity in C. higginsianum
Previous studies have demonstrated that turgor pressure is important factor in the pathogenicity of Colletotrichum [23]. Consistent with these findings, our results revealed that a significant reduction in pathogenicity of both the ChpksΔ and Chthr1Δ mutants on Arabidopsis plants compared to the WT strain. Specifically, while leaves inoculated with the ChpksΔ mutant exhibited a complete loss of pathogenicity, those inoculated with the Chthr1Δ mutant still displayed some typical water-soaked, collapsed anthracnose lesions (Figure 7A). Furthermore, we observed that the ChpksΔ mutant also lost its ability to cause disease on detached leaves of Chinese flowering cabbage; however, when inoculated on wounded leaves, the pathogenicity was restored (Figure 7B). In contrast, there was no significant difference in pathogenicity between the Chthr1Δ mutant and the WT strain when tested on detached leaves of Chinese flowering cabbage (Figure 7B). These findings unequivocally demonstrate that both ChPks and ChThr1 play indispensable roles in mediating pathogenicity in C. higginsianum. Notably, while reduced turgor pressure severely impairs penetration ability in the case of the ChpksΔ mutant, it appears to have a less pronounced effect on this aspect for the Chthr1Δ mutant.
Figure 7.
Analysis of pathogenicity of the ChpksΔ and Chthr1Δ mutants. (A) Symptoms observed on Arabidopsis thaliana plants 5 days post-inoculation with conidial suspensions of the WT, ChpksΔ, Chthr1Δ, ChpksΔ-C and Chthr1Δ-C strains. (B) Symptoms observed on detached leaves of Chinese flowering cabbage 4 days post-inoculation with conidial suspensions of the WT, ChpksΔ, Chthr1Δ, ChpksΔ-C and Chthr1Δ-C strains.
3. Discussion
Melanin is a critical component of fungal cell wall that helps to maintain cell wall integrity and is involved in against environmental stresses, accumulation of turgor pressure and pathogenicity [9,16]. Previous studies have reported that the genus Colletotrichum synthesizes DHN-melanin through the polyketide synthase pathway [5,27,28]. Deficiencies in these enzymes can inhibit or block DHN-melanin biosynthesis in many fungi [25,26,27]. Pks and Thr1 are key enzymes that play a crucial role in the biosynthetic processes of DHN-melanin in several fungi [29,30]. For example, in C. graminicola, CgPKS1 gene encoding polyketide synthase is expressed during appressorial melanization [25]. Similarly, the expression level of BRN2, a homolog of THR1 in Monilinia fructicola and M. fructigena, is noticeably up-regulated during melanin synthesis [31]. In our study, we observed a significant up-regulation of both genes ChPKS and ChTHR1 during hyphal and appressorial melanization processes of C. higginsianum. This finding indicates that ChPks and ChThr1 are essential players in DHN-melanin production. Interestingly, we also found that the expression level of gene ChTHR1 was significantly up-regulated at 40 h post-infection (hpi), suggesting its potential involvement beyond appressorial melanization processes during the biotrophic infection phase of C. higginsianum.
Polyketide synthase (Pks) has been defined as the initial step in the DHN-melanin biosynthetic process [32,33,34]. Deletion of the PKS1 gene in C. graminicola and C. gloeosporioides resulted in colonies that were yellow to light orange in color, indicating a lack of melanization. In addition, appressoria lacking CgPKS1 in C. graminicola showed sensitivity to externally applied cell-wall-degrading enzymes [25,27]. Similarly, deletion of the ChPKS gene led to an orange-yellow colony and unmelanized appressoria. Furthermore, TEM observation revealed that the ChpksΔ mutant did not exhibit any deposits of DHN-melanin dots on its cell wall. This disruption affected the integrity of the cell wall and made it sensitive to agents interfering with cell wall function. Melanin deposition is known to be essential for maintaining turgor pressure within appressoria. For instance, CgPks1Δ mutants exhibited significantly lower turgor pressure compared to WT strains of C. gloeosporioides; however, CgPks1 was found not to play an essential role in penetration and pathogenicity [27]. In contrast, knockout mutants lacking CgPKS1 did not affect turgor pressure but noticeably reduced penetrance and pathogenicity in C. graminicola [25]. These findings indicate that Pks plays different roles among fungal species. In our study with ChpksΔ mutants from C. higginsianum, we observed a significant decrease in turgor pressure within appressoria similar to what was seen with deletion of CgPks1 in C. gloeosporioides due to disrupted cell wall integrity resulting from unmelanized appressoria formation by ChpksΔ mutants. This loss of turgor pressure accumulation led to a loss of penetrance and pathogenicity.
Trihydroxynaphthalene reductase (Thr1) is also a key enzyme in DHN-melanin biosynthesis [35,36,37]. In our study, we observed that the knockout of the gene ChTHR1 resulted in colony and appressoria with limited melanization, as well as a significant reduction in turgor pressure in the Chthr1Δ mutant. This phenotype is similar to that observed in M. oryzae mutants lacking the Buf1 gene encoding trihydroxynaphthalene reductase; however, it should be noted that these Δbuf1 mutants exhibit reduced penetrance [24]. Similarly, disruption of gene THR1 also leads to loss of penetrance in C. lagenarium [26]. Interestingly, our results revealed that the Chthr1Δ mutant was still capable of penetrating Chinese flowering cabbage and Arabidopsis leaves. TEM observation revealed the cell wall of Chthr1Δ mutant fails to form a dense melanin layer, resulting in a notably reduction in turgor pressure and increased sensitivity to cell-wall-interfering agents compared to the WT strains. However, some melanin dots were still deposited on the cell wall of the Chthr1Δ mutant, leading to turgor pressure compared to ChpksΔ mutant. Notably though, this decreased turgor pressure did not affect penetrance. Furthermore, we observed a significant reduction in pathogenicity of Chthr1Δ mutants on Arabidopsis plants when compared to the WT strains. This finding suggests that while ChThr1 may play a role during biotrophic infection phase and contribute to pathogenesis in C. higginsianum, its exact mechanisms require further investigation.
During DHN-melanin biosynthesis of C. higginsianum, the absence of both ChPks and ChThr1 inhibit melanin production. However, compare to the ChpksΔ mutant where DHN-melanin biosynthetic processes is completely blocked, the Chthr1Δ mutant is still able to produce melanin. These results demonstrate that enzymes upstream in the DHN-melanin biosynthesis pathway may have a greater role in DHN-melanin synthesis. Additionally, it has been reported that both reductases Thnr and Thr1 belong to the short-chain dehydrogenase/reductase (SDR) family and share common conserved core structural motifs during DHN-melanin biosynthesis [29]. Studies conducted on C. lagenarium have revealed that Thnr and Thr1 can co-mediate the reduction of T4HN, suggesting functional complementarity between them [38]. However, our results indicate that expression levels of gene ChTHNR was down-regulated in the Chthr1Δ mutant (Figure S5), suggesting that additional mechanisms may be present in C. higginsianum to partially replace the role of ChThr1.
In summary, the deficiency of ChPks completely blocks DHN-melanin biosynthesis, thereby compromising the integrity and rigidity of the cell wall. Consequently, this results in a significant decrease in sensitivity to cell-wall-interfering agents as well as turgor pressure while also reducing pathogenicity in C. higginsianum. It is important to note that despite these effects on melanin production being observed in the Chthr1Δ mutant with limited DHN-melanin biosynthesis occurring within its hyphae and appressoria region, complete loss of pathogenicity has not been observed thus far.
4. Materials and Methods
4.1. Strains, Plant and Culture Conditions
The C. higginsianum IMI 349063 strain used in this study for whole genome sequencing was generously provided by Prof. Junbin Huang of Huazhong Agricultural University (Wuhan, China). All fungal strains were cultured at a temperature of 27 °C.
To assess colony morphology after 5 days cultivated in the dark, the wild type (WT) and all fungal strains were cultivated on PDA medium containing potato extract (200 g/L), dextrose (20 g/L), and agar (20 g/L).
For pathogenicity tests on Arabidopsis thaliana Col-0, the plants were grown for 4 weeks under controlled conditions with a temperature regime of 12 h light/12 h dark at temperatures of 22 °C during the day and 20 °C during the night.
Similarly, Chinese flowering cabbage was used for pathogenicity tests after incubating for 4 weeks under controlled conditions with a constant temperature of 26 °C with a photoperiod of 12 h light/12 h dark.
4.2. Bioinformatics Analysis of ChPks and ChThr1
ChPks protein sequence (XP_018155915) and ChThr1 protein sequence (XP_018155910) were retrieved from the genome database of C. higginsianum IMI 349063 using BLASTp search with C. graminicola PKS1 protein sequence (XP_008093079) and Sclerotinia sclerotiorum Thr1 protein sequence (XP_001586798) as queries. The conserved domains within ChPks and ChThr1 proteins were predicted using Pfam analysis available at http://pfam.xfam.org/ (accessed on 25 August 2023). A neighbor-joining phylogenetic tree was constructed based on amino acid alignments using MEGA X64 10.1.8 software.
4.3. Expression Pattern Analysis of Genes ChPKS and ChTHR1
The WT strain of C. higginsianum was inoculated in PDB (potato 200 g/L, dextrose 20 g/L) medium, and the hyphae was collected at 7, 8, 9 and 10 d for RNA extraction. The expression levels of genes ChPKS and ChTHR1 were determined using real-time quantitative PCR (RT-qPCR), with ACTIN (CH63R_04240) and β-TUBULIN (CH63R_12878) serving as endogenous reference gene. The reverse transcription was performed using TransScript® One-Step gDNA Removal and cDNA Synthesis SuperMix (TransGen Biotech, Beijing, China) according to protocol. The expression levels of genes ChPKS and ChTHR1 were analyzed by RT-qPCR using the Bio-Rad CFX96 Real-Time PCR Detection System and ChamQ Universal SYBR qPCR Master Mix (Vazyme, Nanjing, China). The volume of the RT-qPCR reaction was 20 µL, including 10 µL of 2 × ChamQ Universal SYBR qPCR Master Mix, 0.4 µL Primer-F (10 µM), 0.4 µL Primer-R (10 µM), 2 µL of cDNA (100 ng/µL), and 7.2 µL of ddH2O. The RT-qPCR program consisted of an initial denaturation at 95 °C for 30 s, followed by 40 cycles at 95 °C for 10 s and at 60 °C for 30 s.
Additionally, conidia from the WT strain of C. higginsianum were collected and adjusted to a concentration of 1 × 106 mL−1. Four-week-old A. thaliana Col-0 seedlings were used for inoculation. Samples were taken at various time points including 0 h post-inoculation (hpi), 8 hpi, 22 hpi, 40 hpi and 60 hpi for RNA extraction. RT-qPCR was used to analyze the expression pattern of genes ChPKS and ChTHR1 during infection. Relative expression levels were calculated using the 2−ΔΔCt method. The primers used are shown in Table 1.
Table 1.
List of primers used in this study.
4.4. Deletion and Complementation of ChPKS and ChTHR1
To knockout genes ChPKS and ChTHR1, we constructed knockout plasmids p821-ChPKS-KO and p821-ChTHR1-KO according to the methods described in Figure S3A,B. Fragments of 1000 bp upstream and downstream of genes ChPKS and ChTHR1 were amplified using primer pairs PKS-UP/DS and THR1-UP/DS, respectively. These fragments were then transformed into the ATMT vector pFGL821, resulting in the creation of knockout vectors for the genes ChPKS and ChTHR1, named p821-ChPKS-KO and p821-ChTHR1-KO. Subsequently, the knockout plasmid was transformed into the WT strain using the ATMT technique to replace genes ChPKS and ChTHR1 with HPH1 (hygromycin phosphotransferase gene), respectively. Hygromycin-resistant transformants were isolated as candidate mutants for ChpksΔ and Chthr1Δ. PCR analysis was used to confirm the ChpksΔ and Chthr1Δ mutants (Figure S4). The ChpksΔ and Chthr1Δ mutants were further confirmed by Southern blotting. Using the endonucleases Sma I and EcoR I to digest gDNA of WT and ChpksΔ mutants, and gDNA of WT and Chthr1Δ mutants were digested with Acc65 I. Then, agarose gel electrophoresis to separate the DNA fragment, and transferred to a nylon membrane and assayed using DNA probes specific for ChPKS and ChTHR1, respectively.
Subsequently, for complementation of genes ChPKS and ChTHR1 at their original position, we constructed complementation plasmids pSFZY-ChPKS-COM and pSFZY-ChTHR1-COM according to the methods described in Figure S3C,D. Fragments of 1001–2000 bp upstream, 1000 bp upstream + full length of gene ChPKS and 1000 bp downstream of gene ChPKS were amplified using primer pairs PKSc-F1, F2 and F3. These fragments were transformed into the ATMT vector pSFZY to create a complementary vector for the gene ChPKS, named pSFZY-ChPKS-COM. Additionally, fragments of 1001–2000 bp upstream, 1000 bp upstream + full length of gene ChTHR1, mCherry and 1000 bp downstream of gene ChTHR1 were amplified using primer pairs PKSc-F1, F2, F3 and F4. Subsequently, these fragments were transformed into the ATMT vector pSFZY to create a complementary vector for the gene ChTHR1, named pSFZY-ChTHR1-COM. Similarly, we used the ATMT technique to transform pSFZY-ChPKS-COM and pSFZY-ChTHR1-COM into the ChpksΔ and Chthr1Δ mutants, respectively. Neomycin-resistant transformants were isolated as candidate complementation strains for ChpksΔ-C and Chthr1Δ-C. The presence of these complemented strains was confirmed through PCR analysis (Figure S4A–F). The primers used are shown in Table 1.
4.5. Phenotypic Analysis
All fungal strains were cultured on 6 cm PDA plates at 27 °C under dark conditions, and the colony diameter was measured after 5 d of growth. Additionally, all fungal strains were grown on PDA plates supplemented with specific compounds: 200 μg·mL−1 calcofluor white (CFW), 0.01% sodium dodecyl sulfate (SDS) and 200 μg·mL−1 congo red (CR). The inhibition rate was calculated by measuring the colony diameter after 5 d of growth.
To determine conidiation, the concentration of conidia suspensions for all strains was adjusted to a density of 1 × 106·mL−1, and spread onto 9 cm Mathur plates containing glucose (2.8 g·L−1), MgSO4·7H2O (1.22 g·L−1), KH2PO4 (2.72 g·L−1), oxoid mycological peptone (2.18 g·L−1), and agar (30 g·L−1). After incubation in darkness at 27 °C for 5 days, conidia were washed down with 5 mL of sterile distilled water. Conidiation was determined by measuring the concentration of conidial suspensions using a hemocytometer.
For appressorial formation analysis, the concentration of conidia suspensions for all strains was adjusted to 1 × 105·mL−1. Then, a volume of 20 μL conidia suspensions from each strain was placed on hydrophobic cover glass. After incubating in darkness at 27 °C for 22 h, the rate of appressorial formation was observed and recorded under the microscope. The formation rate of at least 100 appressoria per strain should be assessed.
To assess appressorial turgor, conidia suspensions from all strains were collected and adjusted to a concentration of 1 × 105·mL−1. Subsequently, 20 μL of conidial suspensions from each strain was placed on a hydrophobic cover glass. After incubating in darkness at 27 °C for 22 h, replace the sterile distilled water containing appressoria with a glycerol solution of concentration ranging from 1 to 4 M. Finally, after 10 min of incubation, the rate of appressorial collapse was observed and recorded under the microscope. The collapse rate of at least 100 appressoria per strain should be assessed.
4.6. Transmission Electron and Confocal Microscopy
To observe melanin dots on the cell wall. WT, ChpksΔ and Chthr1Δ strains were cultured in PDB liquid medium for a duration of 10 days prior to conducting transmission electron analysis. Subsequently, hyphae from WT, ChpksΔ and Chthr1Δ strains were collected after 10 d of incubation in PDB and fixed in 2.5% (v/v) glutaraldehyde in 0.1 M sodium phosphate buffer (pH 7.3) at 4 °C for 24 h. They were encapsulated in 3% (w/v) low melting point agarose and then processed in Spurr resin using a Lynx tissue processor on a 24 h schedule. Additional permeation under vacuum at 60 °C was performed before embedding the samples and polymerizing at 60 °C for 48 h, followed by ultrathin sectioning. The observations were made using a Hitachi HT7700 Exalens microscope, alloweing for detailed examination at high resolution levels.
To observe the expression of ChThr1 during the infection of C. higginsianum. The conidia suspension (1 × 105·mL−1) of Chthr1Δ-C was dropped onto the detached Chinese flowering cabbage leaves. The infected leaves were then incubated at a temperature of 27 °C in complete darkness. Fluorescence was observed at 8 h post-infection (hpi), 22 hpi, and 40 hpi using epifluorescence microscopy with a Nikon Instruments A1 Confocal Laser Microscope equipped with a Plan Apochromat 60×/1.27 oil immersion objective. Image analysis was performed using Fiji 1.53q and Affinity Photo 2.0.3 software.
4.7. Pathogenicity Analysis
To assess the pathogenicity of the strains, conidia suspensions (1 × 106·mL−1) were prepared and collected as described previously. These suspensions were then evenly sprayed onto Arabidopsis leaves and subjecting them to a controlled light/dark cycle lasting for 12 h each day at a temperature of 27 °C, Arabidopsis plants were observed and analyzed 4 d after inoculation. Additionally, under constant temperature conditions of 27 °C and in a completely dark environment, 20 μL of conidia suspension was drop onto wounded and unwounded detached Chinese flower cabbage leaves. The Chinese flowering cabbage leaves were observed and analyzed 4 d after inoculation.
Supplementary Materials
The following supporting information can be downloaded at: https://www.mdpi.com/article/10.3390/ijms242115890/s1.
Author Contributions
E.Z. and Y.Z.: conceived and designed the experiments; L.D. and L.W. performed most of the experiments and analyzed the data; W.C. and Z.H.: performed some of the experiments; L.D.: wrote the manuscript; and E.Z. and Y.Z. gave advice and revised the manuscript. All authors have read and agreed to the published version of the manuscript.
Funding
This work was supported by Guangdong Basic and Applied Basic Research Foundation (grant No. 2021A1515011166).
Institutional Review Board Statement
Not applicable.
Informed Consent Statement
Not applicable.
Data Availability Statement
The data presented in this study are available on request from the corresponding author.
Conflicts of Interest
The authors declare no conflict of interest.
References
- Dean, R.; Van Kan, J.A.L.; Pretorius, Z.A.; Hammond-Kosack, K.E.; Di Pietro, A.; Spanu, P.D.; Rudd, J.J.; Dickman, M.; Kahmann, R.; Ellis, J.; et al. The Top 10 fungal pathogens in molecular plant pathology. Mol. Plant Pathol. 2012, 13, 414–430. [Google Scholar] [CrossRef] [PubMed]
- Zhang, H.; Liu, Z.; Zheng, Y.; Huang, H.; Zhou, E.; Yang, M. Identification of resistance to anthracnose in Chinese cabbage variety resources. Guangdong Agric. Sci. 2000, 48, 47–49. [Google Scholar] [CrossRef]
- Damm, U.; O’Connell, R.J.; Groenewald, J.Z.; Crous, P.W. The Colletotrichum destructivum species complex—Hemibiotrophic pathogens of forage and field crops. Stud. Mycol. 2014, 79, 49–84. [Google Scholar] [CrossRef]
- Yan, Y.; Yuan, Q.; Tang, J.; Huang, J.; Hsiang, T.; Wei, Y.; Zheng, L. Colletotrichum higginsianum as a Model for Understanding Host-Pathogen Interactions: A Review. Int. J. Mol. Sci. 2018, 19, 2142. [Google Scholar] [CrossRef]
- Zhu, Y.; Duan, L.; Zhu, C.; Wang, L.; He, Z.; Yang, M.; Zhou, E. Dual Transcriptome Analysis Reveals That ChATG8 Is Required for Fungal Development, Melanization and Pathogenicity during the Interaction between Colletotrichum higginsianum and Arabidopsis thaliana. Int. J. Mol. Sci. 2023, 24, 4376. [Google Scholar] [CrossRef]
- Zampounis, A.; Pigné, S.; Dallery, J.-F.; Wittenberg, A.H.J.; Zhou, S.; Schwartz, D.C.; Thon, M.R.; O’Connell, R.J. Genome Sequence and Annotation of Colletotrichum higginsianum, a Causal Agent of Crucifer Anthracnose Disease. Genome Announc. 2016, 4, e00821-16. [Google Scholar] [CrossRef]
- O’Connell, R.; Herbert, C.; Sreenivasaprasad, S.; Khatib, M.; Esquerre-Tugaye, M.T.; Dumas, B. A novel Arabidopsis-Colletotrichum pathosystem for the molecular dissection of plant-fungal interactions. Mol. Plant Microbe 2004, 17, 272–282. [Google Scholar] [CrossRef]
- Casadevall, A.; Cordero, R.J.B.; Bryan, R.; Nosanchuk, J.; Dadachova, E. Melanin, Radiation, and Energy Transduction in Fungi. Microbiol. Spectr. 2017, 5, 509–514. [Google Scholar] [CrossRef] [PubMed]
- Toledo, A.V.; Franco, M.E.E.; Lopez, S.M.Y.; Troncozo, M.I.; Saparrat, M.C.N.; Balatti, P.A. Melanins in fungi: Types, localization and putative biological roles. Physiol. Mol. Plant Pathol. 2017, 99, 2–6. [Google Scholar] [CrossRef]
- Lin, L.; Xu, J.P. Production of fungal pigments: Molecular processes and their applications. J. Fungi 2022, 9, 44. [Google Scholar] [CrossRef]
- Schumacher, J. DHN melanin biosynthesis in the plant pathogenic fungus Botrytis cinerea is based on two developmentally regulated key enzyme (PKS)-encoding genes. Mol. Microbiol. 2016, 99, 729–748. [Google Scholar] [CrossRef] [PubMed]
- Perez-Cuesta, U.; Aparicio-Fernandez, L.; Guruceaga, X.; Martin-Souto, L.; Abad-Diaz-de-Cerio, A.; Antoran, A.; Buldain, I.; Hernando, F.L.; Ramirez-Garcia, A.; Rementeria, A. Melanin and pyomelanin in Aspergillus fumigatus: From its genetics to host interaction. Int. Microbiol. 2020, 23, 55–63. [Google Scholar] [CrossRef] [PubMed]
- Wang, T.; Ren, D.D.; Guo, H.; Chen, X.; Zhu, P.K.; Nie, H.Z.; Xu, L. CgSCD1 Is Essential for Melanin Biosynthesis and Pathogenicity of Colletotrichum gloeosporioides. Pathogens 2020, 9, 141. [Google Scholar] [CrossRef]
- Pihet, M.; Vandeputte, P.; Tronchin, G.; Renier, G.; Saulnier, P.; Georgeault, S.; Mallet, R.; Chabasse, D.; Symoens, F.; Bouchara, J.P. Melanin is an essential component for the integrity of the cell wall of Aspergillus fumigatus conidia. BMC Microbiol. 2009, 9, 177. [Google Scholar] [CrossRef]
- Eisenman, H.C.; Casadevall, A. Synthesis and assembly of fungal melanin. Appl. Microbiol. Biotechnol. 2012, 93, 931–940. [Google Scholar] [CrossRef] [PubMed]
- Nosanchuk, J.D.; Stark, R.E.; Casadevall, A. Fungal Melanin: What do We Know About Structure? Front. Microbiol. 2015, 6, 1463. [Google Scholar] [CrossRef]
- Bull, A.T. Inhibition of polysaccharases by melanin: Enzyme inhibition in relation to mycolysis. Arch. Biochem. Biophys. 1970, 137, 345–356. [Google Scholar] [CrossRef]
- Munro, C.A.; Gow, N.A.R. Chitin synthesis in human pathogenic fungi. Med. Mycol. 2001, 39, 41–53. [Google Scholar] [CrossRef] [PubMed]
- Walker, C.A.; Gomez, B.L.; Mora-Montes, H.M.; Mackenzie, K.S.; Munro, C.A.; Brown, A.J.P.; Gow, N.A.R.; Kibbler, C.C.; Odds, F.C. Melanin Externalization in Candida albicans Depends on Cell Wall Chitin Structures. Eukaryot. Cell 2010, 9, 1329–1342. [Google Scholar] [CrossRef]
- Eisenman, H.C.; Greer, E.M.; McGrail, C.W. The role of melanins in melanotic fungi for pathogenesis and environmental survival. Appl. Microbiol. Biotechnol. 2020, 104, 4247–4257. [Google Scholar] [CrossRef]
- Zhou, Y.J.; Song, J.J.; Wang, Y.C.; Yang, L.; Wu, M.D.; Li, G.Q.; Zhang, J. Biological characterization of the melanin biosynthesis gene Bcscd1 in the plant pathogenic fungus Botrytis cinerea. Fungal Genet. Biol. 2022, 160, 103693. [Google Scholar] [CrossRef] [PubMed]
- Kunova, A.; Pizzatti, C.; Cortesi, P. Impact of tricyclazole and azoxystrobin on growth, sporulation and secondary infection of the rice blast fungus, Magnaporthe oryzae. Pest Manag. Sci. 2013, 69, 278–284. [Google Scholar] [CrossRef] [PubMed]
- Zhu, W.J.; Xu, X.W.; Peng, F.; Yan, D.Z.; Zhang, S.P.; Xu, R.; Wu, J.; Li, X.; Wei, W.; Chen, W.D. The cyclase-associated protein ChCAP is important for regulation of hyphal growth, appressorial development, penetration, pathogenicity, conidiation, intracellular cAMP level, and stress tolerance in Colletotrichum higginsianum. Plant Sci. 2019, 283, 1–10. [Google Scholar] [CrossRef]
- Zhu, S.; Yan, Y.; Qu, Y.; Wang, J.; Feng, X.; Liu, X.; Lin, F.; Lu, J. Role refinement of melanin synthesis genes by gene knockout reveals their functional diversity in Pyricularia oryzae strains. Microbiol. Res. 2021, 242, 126620. [Google Scholar] [CrossRef] [PubMed]
- Ludwig, N.; Löhrer, M.; Hempel, M.; Mathea, S.; Schliebner, I.; Menzel, M.; Kiesow, A.; Schaffrath, U.; Deising, H.B.; Horbach, R. Melanin Is Not Required for Turgor Generation but Enhances Cell-Wall Rigidity in Appressoria of the Corn Pathogen Colletotrichum graminicola. Mol. Plant Microbe 2014, 27, 315–327. [Google Scholar] [CrossRef]
- Perpetua, N.S.; Kubo, Y.; Yasuda, N.; Takano, Y.; Furusawa, I. Cloning and characterization of a melanin biosynthetic THR1 reductase gene essential for appressorial penetration of Colletotrichum lagenaium. Mol. Plant-Microbe Interact. J. 1996, 9, 323–329. [Google Scholar] [CrossRef]
- Wang, X.; Lu, D.; Tian, C. Analysis of melanin biosynthesis in the plant pathogenic fungus Colletotrichum gloeosporioides. Fungal Biol. 2021, 125, 679–692. [Google Scholar] [CrossRef]
- Qin, X.Y.; Tian, C.M.; Meng, F.L. Comparative Transcriptome Analysis Reveals the Effect of the DHN Melanin Biosynthesis Pathway on the Appressorium Turgor Pressure of the Poplar Anthracnose-Causing Fungus Colletotrichum gloeosporioides. Int. J. Mol. Sci. 2023, 24, 7411. [Google Scholar] [CrossRef] [PubMed]
- Kihara, J.; Moriwaki, A.; Ito, M.; Arase, S.; Honda, Y. Expression of THR1, a 1,3,8-trihydroxynaphthalene reductase gene involved in melanin biosynthesis in the phytopathogenic fungus Bipolaris oryzae, is enhanced by near-ultraviolet radiation. Pigment. Cell Res. 2004, 17, 15–23. [Google Scholar] [CrossRef]
- Zhu, P.K.; LI, Q.; Zhang, C.H.; Na, Y.T.; Xu, L. Bcpks12 gene inactivation substantiates biological functions of sclerotium melanization in Botrytis cinerea. Physiol. Mol. Plant Pathol. 2017, 98, 80–84. [Google Scholar] [CrossRef]
- Verde-Yanez, L.; Vall-Llaura, N.; Usall, J.; Teixido, N.; Torreblanca-Bravo, E.; Torres, R. Identification and Biosynthesis of DHN-melanin Related Pigments in the Pathogenic Fungi Monilinia laxa, M. fructicola, and M. fructigena. J. Fungi 2023, 9, 138. [Google Scholar] [CrossRef]
- Langfelder, K.; Streibel, M.; Jahn, B.; Haase, G.; Brakhage, A.A. Biosynthesis of fungal melanins and their importance for human pathogenic fungi. Fungal Genet. Biol. 2003, 38, 143–158. [Google Scholar] [CrossRef]
- Li, H.; Wang, D.; Zhang, D.D.; Geng, Q.; Li, J.J.; Sheng, R.C.; Xue, H.S.; Zhu, H.; Kong, Z.Q.; Dai, X.F.; et al. A polyketide synthase from Verticillium dahliae modulates melanin biosynthesis and hyphal growth to promote virulence. BMC Biol. 2022, 20, 125. [Google Scholar] [CrossRef] [PubMed]
- Zhang, C.; He, Y.; Zhu, P.; Chen, L.; Wang, Y.; Ni, B.; Xu, L. Loss of bcbrn1 and bcpks13 in Botrytis cinerea Not Only Blocks Melanization But Also Increases Vegetative Growth and Virulence. Mol. Plant Microbe Interact. 2015, 28, 1091–1101. [Google Scholar] [CrossRef] [PubMed]
- Lin, L.; Xu, J.P. Fungal Pigments and Their Roles Associated with Human Health. J. Fungi 2020, 6, 280. [Google Scholar] [CrossRef] [PubMed]
- Zhou, Y.J.; Li, N.; Yang, J.Y.; Yang, L.; Wu, M.D.; Chen, W.D.; Li, G.Q.; Zhang, J. Contrast Between Orange- and Black-Colored Sclerotial Isolates of Botrytis cinerea: Melanogenesis and Ecological Fitness. Plant Dis. 2018, 102, 428–436. [Google Scholar] [CrossRef]
- Liang, Y.; Xiong, W.; Steinkellner, S.; Feng, J. Deficiency of the melanin biosynthesis genes SCD1 and THR1 affects sclerotial development and vegetative growth, but not pathogenicity, in Sclerotinia sclerotiorum. Mol. Plant Pathol. 2018, 19, 1444–1453. [Google Scholar] [CrossRef] [PubMed]
- Tsuji, G.; Sugahara, T.; Fujii, I.; Mori, Y.; Ebizuka, Y.; Shiraishi, T.; Kubo, Y. Evidence for involvement of two naphthol reductases in the first reduction step of melanin biosynthesis pathway of Colletotrichum lagenarium. Mycol. Res. 2003, 107, 854–860. [Google Scholar] [CrossRef]
Disclaimer/Publisher’s Note: The statements, opinions and data contained in all publications are solely those of the individual author(s) and contributor(s) and not of MDPI and/or the editor(s). MDPI and/or the editor(s) disclaim responsibility for any injury to people or property resulting from any ideas, methods, instructions or products referred to in the content. |
© 2023 by the authors. Licensee MDPI, Basel, Switzerland. This article is an open access article distributed under the terms and conditions of the Creative Commons Attribution (CC BY) license (https://creativecommons.org/licenses/by/4.0/).